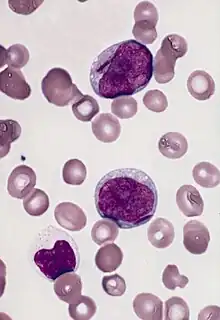

Myéloblaste
Les myéloblastes sont des cellules souches hématopoïétiques unipotentes, qui vont se différencier en membre de la lignée granulocytaire. Une fois stimulés par du Filgrastim (ou G-CSF) et d'autres cytokines, ces myéloblastes maturent, se différencient et prolifèrent. On les retrouve exclusivement dans la moelle osseuse.
Morphologie

Les myéloblastes se trouvent dans la moelle osseuse, où se déroule l'hématopoïèse[1],[2]. Ce sont des cellules plutôt petites, d'un diamètre entre 14 et 18µm et possédant un large noyau ovale, composé de chromatine non condensée et possédant au minimum trois nucléoles, qui servent de lieu de synthèse de protéines ribosomales dispersées dans le cytoplasme[3]. Le cytoplasme est dépourvu de granules et a un aspect basophile, contrairement au promyélocyte, son successeur dans la lignée hématopoïétique. On retrouve également quelques mitochondries de petite taille[3].
On différencie les myéloblastes des lymphoblastes grâce à la présence de granules dans le cytoplasme des myéloblastes et de chromatine moins condensée[4].
Développement
Ces cellules dérivent d'autres cellules souches hématopoïétiques. Si d'autres cellules sont déjà engagées dans des voies de différenciations de cellules sanguines comme l'érythropoïèse, les myéloblastes ne sont pas encore engagés, ces derniers pouvant devenir des cellules engagées dans la granulopoïèse ou dans la monocytopoïèse. L'entrée en granulopoïèse est régulée par des agents humoraux, comme les glycoprotéines CSF-3 ou l'interleukine 3[5].
Fonction
_diagram_en.svg.png)
La granulopoïèse est constituée de cinq étapes, dont le myéloblaste est la première cellule reconnaissable. Ce dernier se différencie ensuite en monoblaste ou en promyélocyte, qui se divise ensuite en l'un des trois types de myélocytes, basophile, neutrophile ou éosinophile.
En pathologie humaine
Des problèmes touchant les myléloblastes conduisent le plus souvent à des leucémies myéloblastiques aiguës, qui conduit généralement à un échec de la formation des cellules sanguines, résultant en anémies et en hémorragies[6]. Ces leucémies se développent via les divisions anarchiques des cellules souches cancéreuses et sont généralement causées par des syndromes myélodysplasiques, des pancytopénies ou des hypoplasies de la moelle épinière[7].
Références
- ↑ (en) Donald Metcalf, « Hematopoietic cytokines », Blood, (lire en ligne [PDF])
- ↑ (en) Kazunori Sasaki, Kazuma Ikeda, Kinya Ogami, Jiro Takahara et Shozo lrino, « Cell-to-Cell Interaction of Cytokine-Dependent Myeloblastic Line Constitutively Expressing Membrane-Bound Stem Cell Factor Abrogates Cytokine Dependency Partially Through Granulocyte-Macrophage Colony-Stimulating Factor Production », Blood, (lire en ligne [PDF])
- 1 2 (en) « Myeloblast », sur Britannica (consulté le )
- ↑ (en) Richard Sheppard Mitchell, Vinay Kumar, Abul K. Abbas et Nelson Fausto, Robbins Basic Pathology, Philadelphie, Saunders, , 8e éd., 946 p.
- ↑ (en) AC Ward, DM Loeb, AA Soede-Bobok, IP Touw et AD Friedman, « Regulation of granulopoiesis by transcription factors and cytokine signals », Nature, (lire en ligne)
- ↑ (en) I. Murohashi, S. Tohda, T. Suzuki, K. Nagata, Y. Yamashita et N. Nara, « Autocrine growth mechanisms of the progenitors of blast cells in acute myeloblastic leukemia », Journal of the American Society of Hematology, no 74, , p. 35-41 (lire en ligne [PDF])
- ↑ (en) N. Villamor, M-A. Zarco, M. Rozman, J-M. Ribera, E. Feliu et E. Montserrat, « Acute myeloblastic leukemia with minimal myeloid differentiation: phenotypical and ultrastructural characteristics », Leukemia, Stockton Press, vol. 12, (lire en ligne)
Annexes
Articles connexes
Bibliographie
- (en) Marjorie J. Williams, « Myeloblastic Leukemia Preceded by Prolonged Hematologic Disorder », Journal of the American society of hematology, no 10, , p. 502-509 (lire en ligne [PDF])
- Portail de l’hématologie